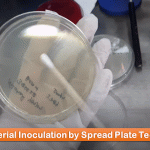

Tag: Streak Plating Technique
Bacterial Inoculation Method: Introduction, Common types, Inoculation Procedure, Uses and Keynotes
 Introduction of Bacterial Inoculation Method The bacterial inoculation method is...
Introduction of Bacterial Inoculation Method The bacterial inoculation method is...
Introduction of Bacterial Inoculation Method The bacterial inoculation method is...
Introduction of Bacterial Inoculation Method The bacterial inoculation method is...